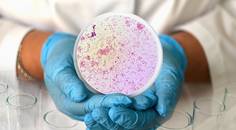
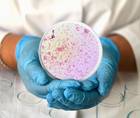

advertisement
Allergy, Asthma, and Immunology
129-144 of 240
- Medical NewsPandemic Fatigue and Vaccine Hesitancy Continue to Affect Global Public Health, New 23-Country Study in Nature Medicine Reports
prnewswire.com
04/30/2024 - Medical NewsPatients with Hidradenitis Suppurativa Have Increased Odds of Respiratory Disease, According to Study Findings
dermatologytimes.com
04/29/2024
eurekalert.org
04/26/2024- Medical NewsExperts Call for Global Genetic Warning System to Combat the Next Pandemic and Antimicrobial Resistance
frontiersin.org
04/26/2024
upi.com
04/25/2024
labroots.com
04/25/2024
today.ucsd.edu
04/25/2024
medicalxpress.com
04/22/2024- Medical NewsCOVID-19 Booster Immunity Lasts Much Longer Than Primary Series Alone, York-Led Study Shows
yorku.ca
04/22/2024
imperial.ac.uk
04/19/2024
phys.org
04/18/2024
news.ucr.edu
04/17/2024
medicalxpress.com
04/15/2024
medicalxpress.com
04/15/2024- Medical NewsDrug in OUtMATCH Clinical Trial FDA-Approved for the Reduction of Allergic Reactions from Accidental Food Exposures
news.unchealthcare.org
04/12/2024